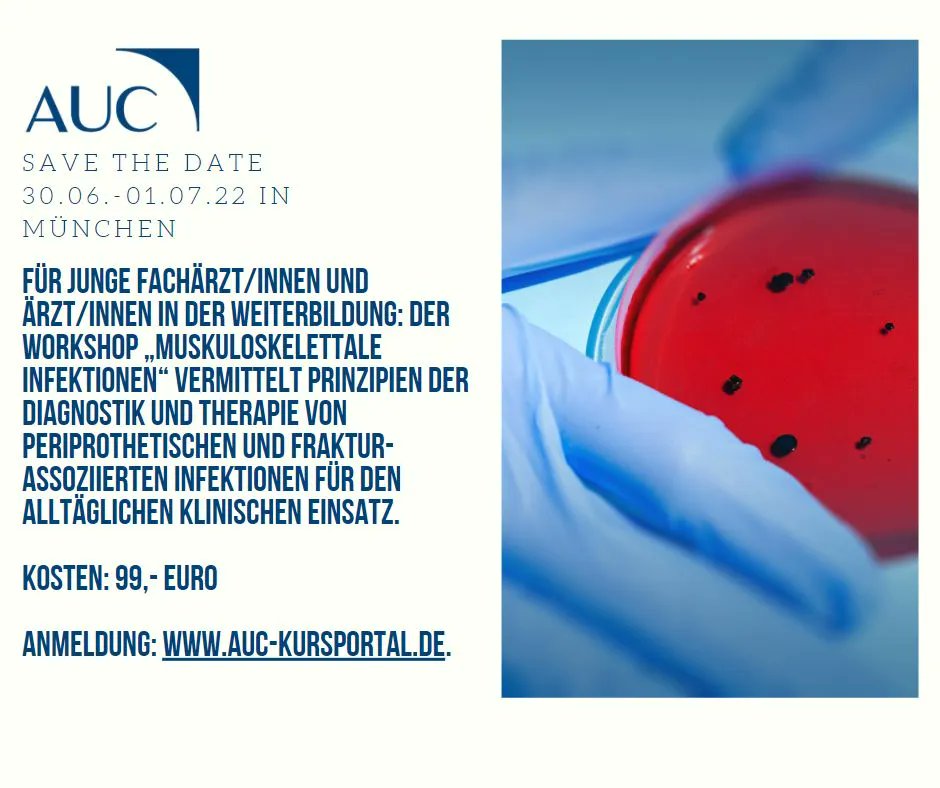
Für junge Fachärzt/innen und Ärzt/innen in der Weiterbildung: Der Workshop „Muskuloskelettale Infektionen“ vermittelt Wissen zur klinischen Therapie von Infektionen bei Frakturen. Vom 30.06. - 01.07.2022 in München, Kosten: 99,- Euro, Anmeldung: bit.ly/3wI4DFH.

AUC - Akademie der Unfallchirurgie GmbH
@auc_de
Wir als AUC arbeiten im Auftrag der Deutschen Gesellschaft für Unfallchirurgie (DGU) an Projekten und Initiativen für die Unfallchirurgie in Deutschland!
ID: 1247599407312375810
https://www.auc-online.de 07-04-2020 18:57:46
229 Tweet
104 Takipçi
24 Takip Edilen




Jetzt anmelden zur Notfallkonferenz der DGU in Hamburg. In Kooperation mit dem Sanitätsdienst der Bundeswehr und der #DGWMP. Online oder vor Ort teilnehmen am 13.05! Schwerpunkt wird die zivil-militärische Zusammenarbeit sein. Anmelden auf bit.ly/30f7fNW #Unfallchirurgie




Nicht verpassen - „Wer ist denn heutzutage noch instabil…? Oder wieviel Intervention im Schockraum können wir akzeptieren?“ Web-Seminar als SideTrail zu unserem #TraumaTrail 2022 von und mit Heiko Trentzsch. Live und kostenfrei um 20:00 Uhr: bit.ly/3jYM2xG #Unfallchirurgie









Heute vor zwei Wochen fand die 4. Notfallkonferenz von DGU und Sanitätsdienst der Bundeswehr in den Räumen der HSU Hamburg statt. Wir danken allen Referenten und Unterstützern!